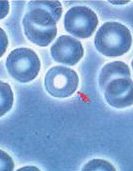
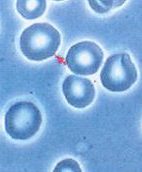
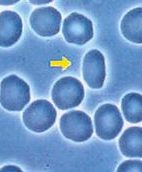

The most easily monitored tissue that shows changes in response to nutritional status is the blood
Live blood analysis is carried out through visual examination of a small droplet of fresh capillary blood, typically taken from the fingertip, and observed under a high-powered light microscope, in dark-field or bright field.
This method offers a qualitative visual perspective of the blood cells and state of the blood plasma at high magnification enhanced by modern optical techniques. It offers a visual perspective on the ecology of the blood, sometimes referred to as the “biological terrain.”

Live blood analysis may provide valuable information about the following:
Although Live Blood Analysis cannot diagnose disease, it can show the impact that lifestyle and diet has had on health
This is of primary importance because the development of degenerative and chronic disease can be prevented with early intervention of lifestyle and dietary changes.
In live blood analysis one can observe the size, shape, variability, and cellular integrity of the red blood cells (RBCs). The stickiness and aggregation of the RBCs are also noted. The presence and relative number of white blood cells and their subtypes are noted, along with the motility (movement) of these cells.
The plasma is checked for platelet aggregates, the formation of fibrin, the presence of microbial and parasitic forms, as well as particulates including cholesterol, crystals, and various contaminants.
Cost is £120 for an hours consultation.

— Normal Blood

— Healthy blood seen in Dark Field

— Unhealthy Blood from a cancer patient
— Anisocytosis
— Echinocytes
— Poikilocytes

— Mycoplasma

— L Forms

— Cholestoral Crystals

— Protplasts
We use a separate dried blood sample and leave it on the slide for 30 mins or more, this allows us to see patterns of degeneration. It gives an indication to which parts of the body or holding on to toxins, creating more of a risk to health.

— Normal live blood

— Normal Dried blood
The initial Live and Dried Blood Microscopy consultation will take 45-mins to an hour. During our time we will assess your current symptom picture, including what foods and medications/supplements you are taking, after the initial health assessment, the live blood is then viewed and discussed with you and a report provided.
Please avoid tea/coffee at least 2-3 hours prior to the test and ensure you are well hydrated.
All we need is a small sample of blood which is taken from your finger (capillary blood). It's painless and there are no side effects.